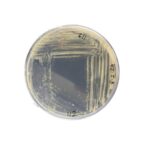

Elkészítette és a napokban weboldalán nyilvánosan elérhetővé is tette fenntarthatósági jelentését a DAV Mérnöki Kft.
Az önkéntes alapon vállalt lépés ma még ritkaságszámba megy az építőiparban, amely világszinten az üvegházhatású gázok kibocsátásának mintegy harmadáért felelős. A rácalmási székhelyű, elsősorban a mezőgazdasági csarnokairól és saját fejlesztésű HungaroSpan ívszerkezeteiről ismert vállalat a dokumentumban számszerűsített adatokat közöl többek közt jelenlegi károsanyag-emissziójáról, és konkrét lépéseket, valamint mérhető célokat is megfogalmaz tevékenysége további zöldítésének érdekében.
„Az utóbbi években az építőiparban is egyértelműen érzékelhető, hogy a megbízók egyre határozottabb igényként, elvárásként fogalmazzák meg potenciális partnereik felé a fenntarthatósággal kapcsolatos tudatosságot. Különösen igaz ez azokra a nagyvállalatokra, amelyeket már érint vagy a közeljövőben érinteni fog az ESG-jelentéstételi kötelezettség, illetve azokra, akik multinacionális piacokon működnek. Ezért is döntöttünk úgy, hogy a szabályozásnak jócskán elébe menve, önkéntes alapon közzétesszük eredményeinket és céljainkat az ESG terén, amely hosszú ideje tevékenységünk központi eleme, mára pedig vállalati stratégiánkba is szervesen beépült”
– fogalmazta meg a 2024-es évre vonatkozó, a nemzetközileg elfogadott GRI szabvány iránymutatásait figyelembe véve született jelentés motivációját Hegyi Tamás, a DAV Mérnöki Kft. ügyvezetője.
A 36 oldalas dokumentumból kiderül például, hogy a vállalat 1 munkavállalóra eső CO2 e kibocsátása 7,09 tonna volt tavaly, ami megfelel az iparági sztenderdnek, de a cégnél természetesen szeretnék ezt évről évre lejjebb faragni. A kibocsátásuk döntő hányadáért (több mint 97%-áért) felelős gázolaj- és benzinfogyasztást például hibrid és elektromos járművek, munkagépek beszerzésével, illetve a szállítási folyamatok racionalizálásával mérsékelnék. A DAV-nál emellett stratégiai cél az épületeik energiafelhasználásának optimalizálása, további napelemes rendszerek telepítése, valamint újrahasznosított csomagolóanyagok használata. Ez utóbbi azért is hangsúlyos, mert az adatgyűjtés szerint 2024-ben munkavállalónként 1,5 m3 csomagolási hulladékuk keletkezett működésük során.
A generáltervező és -kivitelező cégnél a környezettudatosság mellett az ESG társadalmi és vállalatirányítási aspektusai is fókuszban vannak. Közösségi szerepvállalásuk jegyében támogatási nyújtanak többek közt országos vízilabda-egyesületnek, a dunaújvárosi Szent Pantaleon Kórháznak és egy helyi fesztiválnak is. Ezenkívül fokozatosan növelni kívánják női munkavállalóik arányát, valamint az ágazati átlagnál alacsonyabbnak számító, 25%-os fluktuációs rátájukat is lejjebb szorítanák célzott jóléti intézkedésekkel, képzésekkel.
Kiknek kötelező az ESG jelentés?
Magyarországon egy közelmúltbeli módosítást követően a 2025-ös esztendőre nézve a közérdeklődésre számot tartó nagyvállalatoknak, valamint azoknak a cégeknek kötelező ESG jelentést készíteniük, melyek éves árbevétele a tárgyévet megelőző két évben meghaladta a 90 milliárd forintot, az átlagos foglalkoztatotti létszámuk több mint 500 fő és a törvényben rögzített 26 TEÁOR kategória valamelyikébe tartozik a főtevékenységük.
A DAV Mérnöki Kft.-ről
A 2002-ban alapított DAV Mérnöki Kft. mára több mint 300 építőipari projektben vállalt szerepet, főként az üvegházhatású gázok globális kibocsátásának mintegy ötödében érintett agrárium területén. A társaság 2023-as árbevétele 4,573 milliárd forint volt, ami több mint 40%-os növekedés a 2022-es adathoz (3,226 Mrd Ft) képest. 2024 januárjában a vállalatcsoport a fő üzletágak szétválasztásával holdingstruktúrára állt át, a DAV Mérnöki Kft. így kizárólag a csarnokok generáltervezésére és generálkivitelezésére fókuszál. A cég első önálló évében 2,152 milliárd forintos bevételt produkált.
További friss híreket ta
További friss híreket talál az ipar4.hu főoldalán! Kövesse a technológiai híreket és csatlakozzon hozzánk a Facebookon is!